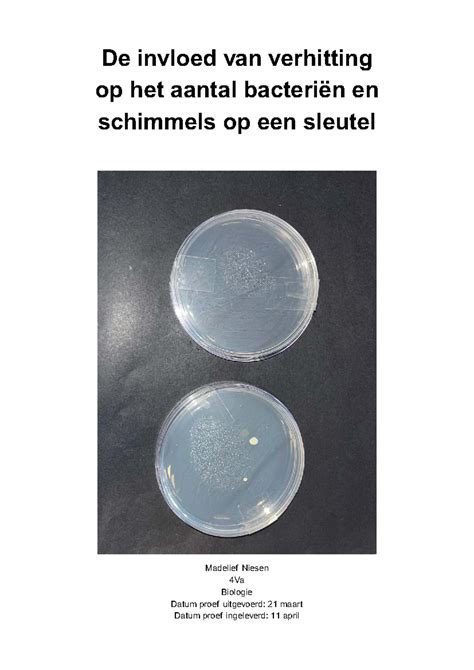
schema van het bereidingsproces van meringue, waarbij de verhitting de bacteriën doodt

Tijdens de zwangerschap is het belangrijk om extra aandacht te besteden aan voeding. Zoetigheden zoals macarons en meringue zijn erg geliefd, maar roepen vaak de vraag op of ze veilig gegeten mogen worden. Dit komt doordat deze lekkernijen traditioneel bereid worden met rauwe eieren, wat een potentieel risico met zich meebrengt.
De Bereiding van Macarons en Meringue
Veel mensen denken dat macarons en meringue niet gegeten mogen worden tijdens de zwangerschap vanwege het gebruik van rauwe eieren. Echter, het bereidingsproces biedt hierin uitkomst. Zowel macarons als meringue worden, voordat ze geconsumeerd worden, verhit in de oven. Dit proces doodt eventuele schadelijke bacteriën, zoals salmonella, die aanwezig kunnen zijn in de rauwe eieren. Hierdoor worden de risico's aanzienlijk verminderd.
Een bekend voorbeeld hiervan is de citroen meringue taart. Vroeger werd deze als risicovol beschouwd voor zwangere vrouwen, maar tegenwoordig is duidelijk dat de bereiding, waarbij de rauwe eieren op een later moment boven de 70 graden worden verwarmd, de salmonella bacterie effectief elimineert.
Voeding tijdens een Feestelijke Gelegenheid
Bij een feestelijke gelegenheid is een aperitief met een mocktail een veilige en bruisende start. Een mocktail, samengesteld uit bijvoorbeeld bruiswater, sinaasappelsap en granaatappelsap, bevat geen alcohol, wat absoluut vermeden dient te worden tijdens de zwangerschap. Bruiswater met fruit biedt ook een feestelijk gevoel zonder risico's.
Hapjes en Kaas: Waar Moet U Op Letten?
Bij het drankje horen natuurlijk hapjes. Toastjes met kaas zien er heerlijk uit, maar het is cruciaal om te informeren naar de herkomst van de kaas. Kazen zoals brie of camembert, die gemaakt zijn van rauwe melk (au lait cru), kunnen listeria bevatten. Deze bacterie kan tijdens de zwangerschap leiden tot ernstige complicaties, zoals vroeggeboorte en miskraam. Daarom worden deze kazen afgeraden.
Groen licht is er voor kaas gemaakt van gepasteuriseerde melk. Deze kaas is veilig om te consumeren tijdens de zwangerschap.

Voorgerechten en Hoofdgerechten: Risico's en Veilige Keuzes
Tijdens het voorgerecht kan carpaccio van rundvlees een verleidelijke keuze lijken, maar dit moet vermeden worden. Rauw rundvlees kan besmet zijn met toxoplasmose of listeria. Als alternatief is een salade met volledig doorbakken kip en goed gewassen groenten een veilige optie. Ongewassen rauwe groenten kunnen immers ook besmet zijn met toxoplasmose.
Het hoofdgerecht biedt uitstekende mogelijkheden voor een gezonde en veilige maaltijd. Gebakken zalm, mits volledig gaar, is een uitstekende keuze. Zalm is rijk aan omega-3-vetzuren, wat essentieel is voor de ontwikkeling van de hersenen van de baby. Het is belangrijk om rauwe of licht gerookte vis, zoals gerookte zalm die niet verhit is, te vermijden, omdat deze nog de listeriabacterie kan bevatten.
Bovendien is het raadzaam om vissoorten te mijden die veel kwik en andere schadelijke stoffen bevatten die de placenta kunnen passeren en een risico vormen voor het ongeboren kind. Voorbeelden van dergelijke vissoorten zijn zwaardvis, tonijn en paling.

Desserts: De Uitdagingen en Veilige Opties
Het dessertbuffet kan een ware uitdaging vormen. Zelfgemaakte gerechten met rauwe eieren, zoals chocolademousse en tiramisu, moeten vermeden worden vanwege het risico op salmonellabesmetting. Hoewel een salmonellabesmetting meestal zonder ernstige gevolgen is, zijn zwangere vrouwen er vatbaarder voor.
Chocomousse uit de winkel is doorgaans veilig, omdat deze producten goed gecontroleerd worden. Gekochte bavarois en tiramisu kunnen echter rauwe eieren bevatten en dienen daarom te worden vermeden.
Wat betreft koffie, deze kan met mate geconsumeerd worden, beperkt tot 1 tot 2 koppen per dag. Cafeïnevrije koffie is een uitstekend alternatief. Kant-en-klare koekjes uit de supermarkt zijn veilig om te eten. Wanneer u zelf iets bakt en rauw ei gebruikt, zorg er dan altijd voor dat het product volledig gaar is.
Voor een snelle en betrouwbare gids over wat u wel en beter niet kunt eten tijdens de zwangerschap, is de gratis app ZwangerHap van het Voedingscentrum een aanrader. Deze app biedt niet alleen productinformatie, maar houdt ook de groei van de baby bij.